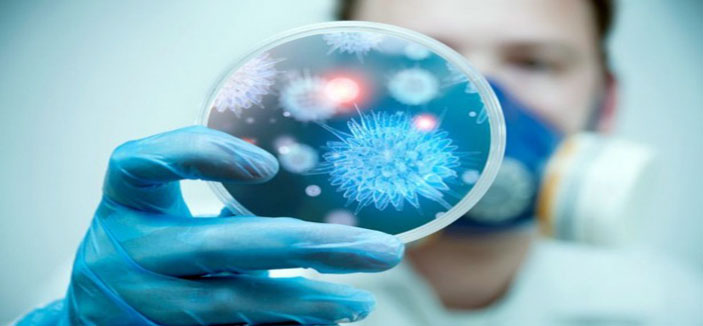

الصحة تؤكد خلو جميع القطاعات الطبية الأهلية حالياً من المرض
5 إصابات بالكرونا في الرياض وحالة وفاة
الجزيرة - أحمد القرني:
تواصل وزارة الصحة في المملكة العربية السعودية اهتمامها ومتابعتها الدقيقة لحالات العدوى بمتلازمة الشرق الأوسط التنفسية (فيروس كورونا) الناشئة عن الحالات التي تم رصدها مؤخراً في منطقة الطائف. بما في ذلك 5 حالات مؤكدة في مدينة الرياض نشأت كعدوى مباشرة من مريض قدم إليها من منطقة الطائف الشهر الماضي.وقد أظهرت التحاليل الطبية إصابة 4 من المرضى والعاملين في الطاقم الطبي في مستشفى الدكتور سليمان الحبيب بالرياض بعدوى متلازمة الشرق الأوسط التنفسية (فيروس كورونا) بعد انتقالها إليهم من المريض المذكور الذي كان قد خضع للتنويم في المستشفى في 18 أكتوبر الماضي حيث انتقل اثنان من المصابين لاحقاً إلى رحمة الله، في حين تماثل الثالث للشفاء وسمح له بالخروج، ولايزال مريض آخر تحت الملاحظة الطبية في المركز المرجعي الذي خصصته وزارة الصحة لحالات الإصابة بفيروس كورونا بالمنطقة الوسطى وهو مستشفى الأمير محمد بن عبدالعزيز.وقد طمأنت الوزارة عبر موقعها الرسمي في «تويتر» بعدم وجود حالات لمرض «كورونا» في جميع القطاعات الصحية الأهلية الخاصة حتى هذه اللحظة، من جانبها أكدت مجموعة الدكتور سليمان الحبيب الطبية إثر إعادتها لتغريدة الوزارة عدم وجود أي حالة مصابة بفيروس كورونا في جميع مستشفياتها.
وأبانت الوزارة أن مركز القيادة والتحكم في وزارة الصحة اكتشف حالات الإصابة من خلال نظام مراقبة الأوبئة لديه وقام مباشرة بإرسال فريق الاستجابة السريعة ليقيم إجراءات منع والتحكم بالعدوى (Rapid Response Team-IPC) في المستشفى المذكور. وبجانب إجراءات التدقيق التي تم اتخاذها فقد، قامت الوزارة بحصر المرضى والعاملين في الطاقم الطبي الذين كانوا على اتصال مع المريض المذكور لتقييم ومتابعة حالاتهم. حيث تم فحص أكثر من 200 مخالط من العاملين في الطاقم الطبي ومن عائلات المصابين للتأكد من عدم إصابتهم بفيروس كورونا.
وأوضح الدكتور أنيس سندي نائب رئيس مركز القيادة والتحكم بوزارة الصحة أن فيروس كورونا مازال نشطاً مما يوجب علينا أن نظل في حالة تيقظ وتأهب كاملة مؤكداً أن بوسع العاملين في القطاع الطبي الحد من خطر العدوى من خلال مواصلة أخذ كل الاحتياطات اللازمة لحماية أنفسهم ومرضاهم على حد سواء.
لافتاً أن مركز القيادة والتحكم يواصل العمل المشترك مع منظمة الصحة العالمية و المركز الأمريكي للوقايه من الأمراض و مكافحة العدوى (CDC) في التحقيق في الحالات الأصلية بمنطقة الطائف التي انتقلت منها العدوى.من جانبه قال الدكتور عبد الله عسيري وكيل وزارة الصحة المساعد للصحة الوقائية والمنسق مع منظمة الصحة العالمية أن مرضى الغسيل الكلوي يعانون من ضعف في جهاز المناعة لديهم مما يجعلهم معرضين لخطر انتقال العدوي بفيروس كورونا بنسبة أكبر من المرضى العاديين ولا تظهر عليهم الاعراض المعتادة للمرض، مما يستوجب على المستشفيات أن نراقب هؤلاء المرضى عن كثب وتقوم بعزلهم فور ظهور أي أعراض عليهم».
من جهة أخرى قام كل من الدكتور أنيس سندي والدكتور عبد الله عسيري لاحقاً بزيارة المستشفى، حيث يواصلان حالياً مراقبة الوضع عن كثب مع فريق وزاري من خبراء الصحة العامة والتحكم بالعدوى. كما أن مديرية الشئون الصحية في المنطقة قد قامت، بناءا على التوصيات المقدمة لها من قبل مركز القيادة والتحكم، بإرسال فريقاً خاصاً إلى المستشفى للتأكد من أن الإجراءات الوقائية اللازمة يتم اتباعها على أكمل وجه وأن التوصيات المقدمة قيد التطبيق الفعلي.
الجدير بالذكر أن وزارة الصحة في المملكة العربية السعودية، وبالاشتراك مع منظمة الصحة العالمية و المركز الأمريكي للوقايه من الأمراض و مكافحة العدوى (CDC)، قامت بتطبيق عدداً من الإجراءات الوقائية لحماية المرضى والعاملين في القطاع الطبي من الإصابة بعدوى متلازمة الشرق الأوسط التنفسية (فيروس كورونا).
تشمل تلك الإجراءات اختبارات ملائمة الأقنعة الواقية التي تجرى للعاملين في القطاع الطبي، وإخضاعهم لدورات تدريبية مستمرة على الإجراءات الواجب اتباعها للكشف عن الحالات المشتبه بإصابتها بفيروس كورونا وكيفية التعامل معها بشكل فوري ، كما أن مرضى متلازمة الشرق الأوسط التنفسية (فيروس كورونا) يتم نقلهم، كلما أمكن ذلك، إلى المراكز المخصصة لعلاجهم حيث تم تخصيص مستشفى الأمير محمد بن عبد العزيز ليكون المركز المرجعي لمتلازمة الشرق الأوسط التنفسية في المنطقة الوسطى.
كما قامت الوزارة بتطوير قوانين جديدة وتدريب ألاف العاملين في القطاع الطبي على كيفية الحد من خطر الإصابة بالعدوى في المستشفيات.
ويتم حاليا القيام بأكثر من 30 مشروعا بحثياً بالتعاون مع الجهات العلمية المحلية والدولية، من بينها دراسة التحكم بالحالات الحرجة المصممة للكشف عن الأسباب المؤدية للإصابة بعدوى متلازمة الشرق الأوسط التنفسية (فيروس كورونا) في المملكة العربية السعودية.تجدر الإشارة أن عدد حالات الإصابة بمتلازمة الشرق الأوسط التنفسية (فيروس كورونا) بلغ على أقل تقدير 796 حالة مؤكدة في المملكة العربية السعودية منذ ظهوره في يونيو 2012.
ودعت الوزارةالجميع إلى زيارة موقع مركز القيادة والتحكم بوزارة الصحة على الإنترنت للحصول على أحدث الإحصائيات وللتعرف على طرق الوقاية من العدوى:
https://www.moh.gov.sa/en/CCC/Pages/defau